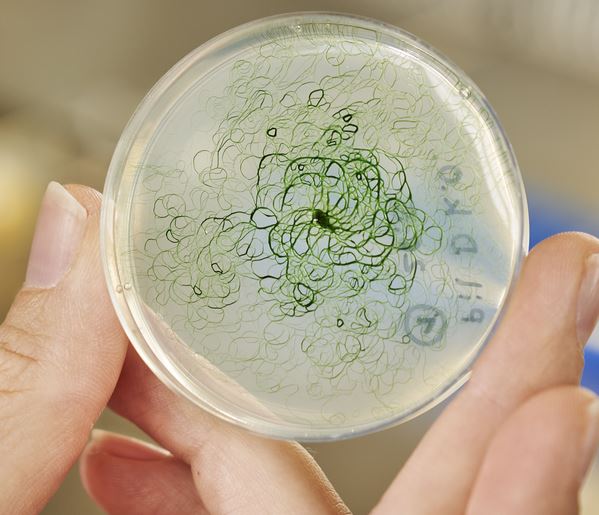

Fraunhofer demonstriert Verfahren zu Produktion klimaneutraler Kraftstoffe aus Klärschlamm
EU-Forschungsprojekt zu alternativen Kraftstoffen abgeschlossen
 Im Projekt „To-Syn-Fuel“ wurde ein vom Fraunhofer Institut UMSICHT entwickeltes Verfahren zur Herstellung von Kraftstoffen aus Biomassereststoffen im Demonstrationsmaßstab umgesetzt. Aus 500 Tonnen Klärschlamm wurden laut einer Medienmitteilung vom 05.10.2022 bislang mehr als 50.000 Liter biogenes Rohöl gewonnen. Der Bau eines Großdemonstrators im bayerischen Hohenburg (Landkreis Amberg-Sulzbach) wurde im Rahmen eines EU-Vorhabens von 11 europäischen Partnern mit 12,5 Millionen Euro gefördert. Zum Abschluss des Projekts absolvierte ein Testfahrzeug mit dem Kraftstoff eine Rundreise von mehr als 2.000 Kilometern durch Europa. (Foto: Fraunhofer Groß-Demonstrator für die dezentrale Konversion von Klärschlamm in Benzin- und Dieselkraftstoff, und die Erzeugung von grünem Wasserstoff – © Fraunhofer UMSICHT) weiterlesen…
Im Projekt „To-Syn-Fuel“ wurde ein vom Fraunhofer Institut UMSICHT entwickeltes Verfahren zur Herstellung von Kraftstoffen aus Biomassereststoffen im Demonstrationsmaßstab umgesetzt. Aus 500 Tonnen Klärschlamm wurden laut einer Medienmitteilung vom 05.10.2022 bislang mehr als 50.000 Liter biogenes Rohöl gewonnen. Der Bau eines Großdemonstrators im bayerischen Hohenburg (Landkreis Amberg-Sulzbach) wurde im Rahmen eines EU-Vorhabens von 11 europäischen Partnern mit 12,5 Millionen Euro gefördert. Zum Abschluss des Projekts absolvierte ein Testfahrzeug mit dem Kraftstoff eine Rundreise von mehr als 2.000 Kilometern durch Europa. (Foto: Fraunhofer Groß-Demonstrator für die dezentrale Konversion von Klärschlamm in Benzin- und Dieselkraftstoff, und die Erzeugung von grünem Wasserstoff – © Fraunhofer UMSICHT) weiterlesen…
 Forschende der TU Darmstadt haben einen wichtigen Erfolg zur Produktion von nachhaltigen Biotreibstoffen für den Transportsektor erzielt. Mit einer neuen Vergasertechnologie gelang es ihnen weltweit erstmalig, ohne zusätzliche externe Energie biogene Reststoffe wie Weizenstroh zu stofflich nutzbarem Synthesegas umzuwandeln. Die Wissenschaftler des
Forschende der TU Darmstadt haben einen wichtigen Erfolg zur Produktion von nachhaltigen Biotreibstoffen für den Transportsektor erzielt. Mit einer neuen Vergasertechnologie gelang es ihnen weltweit erstmalig, ohne zusätzliche externe Energie biogene Reststoffe wie Weizenstroh zu stofflich nutzbarem Synthesegas umzuwandeln. Die Wissenschaftler des  Methanotrophe Bakterien verbrauchen jährlich 30 Millionen Tonnen Methan und faszinieren die Forscher durch ihre natürliche Fähigkeit, das starke Treibhausgas in nutzbaren Brennstoff umzuwandeln. Dennoch wissen wir nur sehr wenig darüber, wie diese komplexe Reaktion abläuft, was unsere Möglichkeiten einschränkt, den doppelten Nutzen zu unserem Vorteil zu nutzen. Durch die Untersuchung des Enzyms, das die Bakterien zur Katalyse der Reaktion verwenden, hat ein
Methanotrophe Bakterien verbrauchen jährlich 30 Millionen Tonnen Methan und faszinieren die Forscher durch ihre natürliche Fähigkeit, das starke Treibhausgas in nutzbaren Brennstoff umzuwandeln. Dennoch wissen wir nur sehr wenig darüber, wie diese komplexe Reaktion abläuft, was unsere Möglichkeiten einschränkt, den doppelten Nutzen zu unserem Vorteil zu nutzen. Durch die Untersuchung des Enzyms, das die Bakterien zur Katalyse der Reaktion verwenden, hat ein  Um der Abhängigkeit von Erdöl, Gas und Kohle entgegenzuwirken und die Nutzung nachwachsender Rohstoffe voranzutreiben, erforscht die
Um der Abhängigkeit von Erdöl, Gas und Kohle entgegenzuwirken und die Nutzung nachwachsender Rohstoffe voranzutreiben, erforscht die  Laut der
Laut der  „Der durch E-Fuels hervorgerufene CO2-Ausstoß wird in Deutschland 2050 rund 76 Mio. Tonnen betragen. Dies entspräche mehr als 40 Prozent des derzeitigen Ausstoßes der heimischen Industrie“, schreibt
„Der durch E-Fuels hervorgerufene CO2-Ausstoß wird in Deutschland 2050 rund 76 Mio. Tonnen betragen. Dies entspräche mehr als 40 Prozent des derzeitigen Ausstoßes der heimischen Industrie“, schreibt Cyanobakterien brauchen kaum Nährstoffe und nutzen die Energie des Sonnenlichts. Badegäste kennen die – oft fälschlich „Blaualgen“ genannten – Mikroorganismen von ihrem Auftreten in Gewässern. Eine Forschergruppe am
Cyanobakterien brauchen kaum Nährstoffe und nutzen die Energie des Sonnenlichts. Badegäste kennen die – oft fälschlich „Blaualgen“ genannten – Mikroorganismen von ihrem Auftreten in Gewässern. Eine Forschergruppe am  Untersuchung zeigt zwar „vermehrte Nachfrage nach Palm- und Sojaöl, aber deren Anbau gefährdet Ökosysteme und trägt zur Klimakrise bei“, so
Untersuchung zeigt zwar „vermehrte Nachfrage nach Palm- und Sojaöl, aber deren Anbau gefährdet Ökosysteme und trägt zur Klimakrise bei“, so  Die umfassende Einbeziehung von Mobilität und Wärmemarkt in die Verringerung der Treibhausgasemissionen ist für einen wirksamen Klimaschutz und für die Verwirklichung der Energiewende unerlässlich. Ein von der
Die umfassende Einbeziehung von Mobilität und Wärmemarkt in die Verringerung der Treibhausgasemissionen ist für einen wirksamen Klimaschutz und für die Verwirklichung der Energiewende unerlässlich. Ein von der  Indiens Premierminister Narendra Modi eröffnete der Plattform
Indiens Premierminister Narendra Modi eröffnete der Plattform